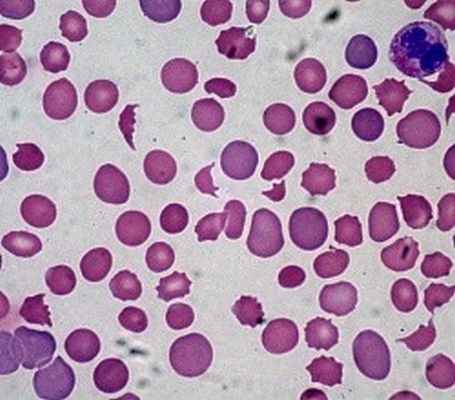
Фото

Гемолитические анемии. Клиника гемолитических анемий
Добавил пользователь Владимир З. Обновлено: 27.01.2026
Аутоиммунная гемолитическая анемия (АИГА) — группа редких приобретенных гематологических болезней и синдромов, характеризующихся гемолизом (разрушением) эритроцитов, вследствие образования аутоантител к антигенам этих компонентов крови.
АИГА может возникнуть в любом возрасте, чаще ей подвержены женщины (60%). Патология развивается постепенно или внезапно.
Выделяют два основных типа АИГА: тепловую (аутоантитела наиболее активны/атакуют эритроциты при температуре 37-40 °C) и холодовую — с холодовыми гемолизинами (аутоантитела наиболее активны при температуре менее 30 °C, эритроциты разрушаются даже при локальном воздействии холода, например, когда человек пьет холодную воду или моет руки в холодной воде).
Причины
Причины возникновения заболевания изучены недостаточно. На сегодняшний день известно, что примерно 50% случаев т-АИГА являются идиопатическими (развиваются спонтанно). Тогда как х-АИГА ассоциированы с другими заболеваниями или возникают с ними одновременно: аутоиммунными, онкологическими, инфекционными (системная красная волчанка, лимфолейкоз, неходжкинская лимфома, вирус Эпштейна — Барр, цитомегаловирус, микоплазменная пневмония, гепатит, ВИЧ). Играть роль в развитии АИГА может и прием определенных лекарств, например, препаратов пенициллинового ряда (лекарственно индуцированная АИГА).
Симптомы
У некоторых людей заболевание может протекать бессимптомно, особенно если АИГА развивается постепенно (разрушение эритроцитов не настолько масштабно). В основном же симптомы АИГА схожи с клиническими проявлениями других типов анемии (слабость, повышенная утомляемость, бледность кожных покровов).
Симптомы при более тяжелом течении заболевания (быстром разрушении эритроцитов) включают желтушность кожных покровов и видимых слизистых оболочек, слабость, повышенную утомляемость с тахикардией и одышкой при физической нагрузке, ощущение дискомфорта в животе, чувство переполнения, холодные конечности и периферический цианоз (при холодовой АИГА). При физикальном осмотре выявляется спленомегалия (патологическое увеличение размеров селезенки) различной степени.
Если АИГА развивается на фоне другой патологии, преобладать могут симптомы основного заболевания, например: увеличение и болезненность лимфатических узлов, лихорадка, сильные боли в спине и ногах, головные боли, рвота, диарея, изменение цвета мочи на темно-коричневый.
Диагностика
Диагностика АИГА включает физикальный осмотр, общий и биохимический анализы крови, морфологическое исследование эритроцитов. Основным критерием диагностического поиска является определение аутоантител с помощью прямого антиглобулинового теста (прямой пробы Кумбса).
Лечение аутоиммунной гемолитической анемии
Первой линией терапии тепловой аутоиммунной гемолитической анемии являются глюкокортикостероиды. Высокодозная монотерапия преднизолоном может назначаться в течение 3-6 недель с постепенным снижением дозы или отменой в дальнейшем. Однако из-за сильно выраженных побочных эффектов такого лечения все чаще используют краткосрочную пульс-терапию метилпреднизолоном или дексаметазоном. Примерно треть пациентов достигают ремиссии, остальным же необходима поддерживающая терапия ГКС.
При неэффективности стероидной терапии рассматривается возможность проведения спленэктомии (хирургическое удаление селезенки), биологической терапии (ритуксимаб) или иммуносупрессивной терапии (циклоспорин, азатиоприн и др.).
Прогноз зависит от первопричины заболевания, своевременно начатого и правильно подобранного лечения. Благоприятный прогноз (достижение ремиссии, длительная ремиссия) полностью связан с положительным терапевтическим ответом у пациента и отсутствием осложнений.
Пациентам с холодовой аутоиммунной гемолитической анемией рекомендуется избегать триггеров (холода, в том числе инфузий холодных растворов), а также пройти лечение основного заболевания (например, лимфомы), если с ним связано развитие х-АИГА. Терапия первой линии при х-АИГА — ритуксимаб. ГКС не является терапией выбора из-за низкого терапевтического ответа у пациентов. Также неэффективна и спленэктомия. В тяжелых случаях рекомендован плазмоферез.
Особенности и преимущества лечения аутоиммунной гемолитической анемии в клинике Рассвет
Аутоиммунная гемолитическая анемия достаточно редкое заболевание крови, по мере его изучения критерии диагностики и лечения дорабатываются и обновляются.
Гематологи клиники Рассвет придерживаются стандартизированных диагностических критериев и терапевтических подходов, разработанных Международной консенсусной группой по АИГА. Мы осознаем важность точного диагностического поиска у таких пациентов, поскольку течение заболевания и эффективное лечение зависят от типа задействованных антител. Для диагностики первичной АИГА мы используем моноспецифический прямой антиглобулиновый тест, обязательно выясняем причины манифестации вторичной АИГА, т. е. выявляем основное заболевание, с которым связано развитие гемолитической анемии.
При лечении т-АИГА мы используем глюкокортикостероиды. Ритуксимаб назначаем только на раннем этапе тяжелого течения заболевания, а также при отсутствии быстрого терапевтического ответа на стероиды. Ритуксимаб в сочетании с антинеопластическим препаратом назначаем пациентам с х-АИГА в случаях, если их состояние требует лечения по клиническим признакам.
Гематология Рассвета представлена врачами высокой квалификации, имеющими большой опыт в выявлении и лечении сложнодиагностируемых и редких болезней. В своей работе наши специалисты используют международные протоколы лечения, применяют только безопасные, доказанные и эффективные методы.
Гемолитическая анемия
Гемолитическая анемия – совокупность нечасто встречающихся заболеваний, характерной чертой которых является сокращение продолжительности жизни красных кровяных клеток из-за их интенсивного разрушения. Уничтожение эритроцитов происходит быстрее, чем успевают появляться новые клетки.
Внимание!
Здесь вы сможете выбрать врача, занимающегося лечением Гемолитическая анемия Если вы не уверены в диагнозе, запишитесь на прием к терапевту или врачу общей практики для уточнения диагноза.
Статьи на тему Гемолитическая анемия:
Причины
Симптомы
Диагностика
Лечение
Осложнения
Профилактика
Какой врач лечит Гемолитическая анемия
Кандидат медицинских наук, врач-гематолог высшей категории, занимается лечением лейкоза, лимфом, лимфогранулематоза и других онкологических поражений крови и кроветворной системы.
И.А. Родионова занимается диагностикой и лечением анемий, нарушений свертываемости крови, лейкемий острых и хронических, лимфомы Ходжкина и неходжкинских злокачественных лимфом, идиопатической тромбоцитопенической пурпуры. Проводит оценку тромбофилических рисков перед оперативными вмешательствами и перед началом приема гормональных лекарственных препаратов (комбинированных оральных контрацептивов, заместительной гормональной терапии). Автор 7 научных работ.
Доктор Киселева посвятила лечению болезней крови свыше 20 лет. Она является гематологом высшей категории, который постоянно совершенствует профессиональные знания, посещая конгрессы и конференции гематологов
Харьковское шоссе, 121, Киевская городская клиническая больница №1, 1-й этаж палатного корпуса на карте
Данное заболевание можно разделить на несколько форм:
- врожденные анемии – характеризуются распадом эритроцитов в результате генетических дефектов:
- мембранопатии эритроцитов – на генетическом уровне нарушается оболочка эритроцитов, что приводит к их быстрому распаду;
- энзимопатии (ферментопатии) – быстрый распад обусловлен дефицитом активности эритроцитарных ферментов (чаще всего это глюкозо-6-фосфатдегидрогеназы);
- гемоглобинопатии – разновидность анемий, которые связаны с нарушениями структур белка гемоглобина на генетическом уровне;
- дефект мембраны эритроцитов – заболевание, которое встречается крайне редко. Для него свойственным является распад красных кровяных клеток во время сна;
- внеэритроцитальная патология – явление, при котором причиной распада служит не нарушение внутри самой клетки, а повреждение различными внешними факторами;
- иммуногемолитические анемии (аутоиммунная гемолитическая анемия и изоимунная) – возникают из-за того, что организм вырабатывает антитела, уничтожающие собственные красные кровяные клетки. Причиной этого может служить нарушение в работе иммунной системы (например, при раке крови);
- анемии, возникновение которых связано с повышенным разрушением красных кровяных клеток в селезенке (например, при циррозе печени);
- анемии, возникающие вследствие механических повреждений оболочек эритроцитов (встречается при протезировании сердечных клапанов);
- токсических веществ на эритроциты (например, отравление ядами, тяжелыми металлами, свинцом);
- при инфекционно-токсическом поражении организма (путем воздействия паразитов);
- анемии, возникшие в результате нехватки витамина Е в организме, который напрямую влияет на прочность оболочки эритроцита.
Причины
На появление гемолитической анемии могут оказать воздействие следующие причины:
- наследственные гемолитические анемии, при которых дефективный ген передается ребенку от одного или обоих родителей;
- спонтанная мутация на генетическом уровне в период внутриутробного развития плода приводит к тому, что развивается гемолитическая анемия у детей.
В случае наличия дефектного гена, вызывающего данное заболевание, в обоих лоскутках хромосомы, речь идет о гомозиготной форме. Шансы дожить до зрелого возраста у больных с данным диагнозом практически нулевые.
Приобретенные гемолитические анемии:
- возникают в результате длительного воздействия химических веществ или медицинских препаратов на организм;
- анемии, возникающие из-за влияния на организм инфекций, вызванных бактериями или паразитами (например, малярия);
- анемию может вызвать обширный ожог, из-за которого произошло отравление организма ядами;
- причины, связанные с иммунной системой, например, несовместимость группы крови при переливании, выработка антител в организме против своих же эритроцитов, механические повреждения красных кровяных клеток, недостаток витамина Е в организме.
Симптомы
При гемолитической анемии симптомы ярко выражены и выглядят следующим образом:
- кожа и слизистые оболочки рта и глаз приобретают бледный или желтушный цвет (в результате наличия продуктов распада кровяных телец в организме);
- сердцебиение учащается;
- наблюдается общая слабость в организме, быстрая утомляемость, одышка;
- увеличивается печень и селезенка;
- повышается уровень билирубина и развивается желтуха (кожный покров, белки глаз, слюна и слезная жидкость приобретает лимонный цвет);
- повышается температура тела, появляются приступы головокружений;
- иногда наблюдаются расстройство сознания и мышечные судороги;
- характерным симптомом является повышение густоты крови, вследствие чего наблюдается плохая циркуляция крови, насыщение кислородом происходит слабо, образуются тромбы, нарушается кровоснабжение внутренних органов.
Диагностика
Для определения гемолитической анемии диагностика проводится следующим образом:
- проводится анализ жалоб:
- как давно наблюдаются такие симптомы как слабость, общее недомогание организма. Какой цвет у кожного покрова (желтушность указывает на наличие анемии)? Какого цвета слизистая глазных белков, нет ли потемнения мочи;
- проводится анализ анамнеза заболевания: не наблюдалось ли данное заболевание у кого-то из родственников, не подвергался ли организм влиянию химических средств, нет ли заболеваний крови или иммунной системы;
- клинический анализ крови – для определения уровня гемоглобина и эритроцитов в крови;
- анализ крови и мочи на определение билирубина;
- исследование формы красных кровяных клеток, так как анемия может развиться из-за неправильной формы эритроцитов;
- проба Кумбса – метод, с помощью которого определяют реакцию антител по отношению к эритроцитам;
- ультразвуковое исследование области брюшины для определения размеров печени и селезенки (УЗИ);
- для исследования кроветворной системы делают пункцию костного мозга;
- проводится консультация у терапевта.
Лечение
При гемолитической анемии лечение проводится при помощи следующих методов:
- назначаются медикаментозные препараты, такие как глюкокортикостероиды, которые снимают воспаление и иммунодепрессанты (назначают в случае сбоя в иммунной системе, для подавления аутоиммунных реакций);
- если в основе заболевания лежит недостаток ферментов в красных кровяных клетках, то недостающие ферменты назначают принимать медикаментозно;
- если болезнь возникла из-за разрушения эритроцитов в селезенке, то назначается хирургическое удаление селезенки – спленэктомия;
- плазмоферез – процедура, в основе которой лежит удаление из крови плазмы, в которой содержатся токсические вещества и продукты распада обмена веществ;
- переливание очищенных донорских эритроцитов. Очищение подразумевает удаление чужеродного белка с поверхности красных кровяных клеток;
- пересадка костного мозга.
Осложнения
- сердечно-сосудистая недостаточность из-за ряда факторов, влияющих на сократительную способность сердца;
- острая почечная недостаточность;
- разрывы селезенки;
- инфаркт;
- синдром внутрисосудистого свертывания крови, в результате которого происходит кровоизлияние в различные внутренние органы, кожные и слизистые покровы и полости организма;
- анемическая кома.
Профилактика
В случае наследственной предрасположенности необходимо проконсультироваться у врача-генетика на стадии планирования беременности и заранее определить резус-фактор крови. Рекомендуется принимать меры по укреплению иммунной системы, а именно:
- правильное дробное питание;
- отказ от вредных привычек;
- соблюдение режима сна;
- пребывание на свежем воздухе;
- употребление витаминов в осенне-зимний период.
При обнаружении любого из этих симптомов необходимо проконсультироваться с врачом - гематологом. Он поможет подобрать схему лечения, исходя из особенностей вашего организма. На нашем портале также доступен широкий выбор препаратов. Вы можете максимально быстро найти нужный препарат в разделе "Аптека".
Гемолитическая анемия
Гемолитическая анемия — это гетерогенное заболевание, которое характеризуется патологическим, повреждением и последующим распадом эритроцитов (гемолизом).
Различают наследственные и приобретенные гемолитические анемии,связанные и несвязанные с дефектом эритроцитов. Часто встречаются аутоиммунные гемолитические анемии, при которых эритроциты разрушаются антителами, вырабатываемыми самим организмом.
Эритроциты — это красные кровяные тельца, курсируют в кровеносном русле и переносят кислород к органам, и забирает у них углекислоту. В норме клетка живет примерно 120 дней и после этого сама уничтожается в селезенке.
Если в организме мало эритроцитов, то он получает мало кислорода, что и вызывает сбои в работе всего организма.
![]()
Этиология развития гемолитической анемии
Существует две больших причины развития гемолитической анемии:
Врожденные. Чаще всего, это разные дефекты развития эритроцитов, что передаются по наследству от родителей к ребенку. Он включает серповидноклеточную анемию, талассемию. Это приводит к тому , что эритроциты, не живут так долго, как нормальные клетки.
Приобретенные. К этой группе причин относят так называемую иммунную гемолитическую анемию, ее может спровоцировать:
- Неконтролируемый прием антибиотиков, парацетамола, препаратов от малярии;
- Инфекционные заболевания;
- Онкологические заболевания;
- Аутоиммунные расстройства
- Ревматоидный артрит, системная волчанка, и много других аутоиммунных заболеваний;
- Увеличение активности и размера селезенки и она начинает уничтожать слишком большое количество эритроцитов;
- Искусственные сердечные клапаны, которые своими ударами могут повреждать эритроциты;
Клинические проявления
Симптоматика гемолитической анемии может быть острой и развиваться быстро или хронической. К основным симптомам относят:
- Патологическая бледность и/или желтушность кожи. Из-за отсутствия эритроцитов, кожа теряет свой естественный цвет.
- Постоянная усталость, слабость, снижение физической активности .
- Головокружения, боли в голове и спутанность сознания.
- Снижение или отсутствие аппетита.
- Увеличения сердцебиения, даже в полном покое.
- Обострения хронических болезней.
- Одышка;
- Снижения артериального давления.
- Желтуха в период острой потери эритроцитов.
- Увеличение размера печени и селезенки.
- Постоянно холодные конечности.
- Боль в груди.
![]()
Также дополнительно добавляются симптомы сопутствующих заболеваний, которые могут усилить гемолитическую анемию: повышение температуры, боли в суставах, гормональные нарушения.
В случае критической анемии у пациента может быть потеря сознания, сонливость, апатия и полное отсутствие сил. В таком случае необходимо проводить лечение только в реанимационном стационаре.
Особенности гемолитической анемии у детей
Так как одной из причин гемолитической анемии является наследственность, то и проявляется болезнь зачастую в новорожденном возрасте. Такие дети могут иметь особые анатомические черты: патологическое изменение челюсти и зубов, полидактилия, деформация шейного отдела позвонка, башенный череп и много других. Подробнее
![]()
Диагностические мероприятия
Все начинается с детального сбора жалоб и анамнеза: что именно беспокоит когда началось, периоды обострения и ремиссии, историю болезни за жизнь и много другого
С целью дифференциальной диагностики врач направляет пациента на анализы:
- Общий анализ крови с развернутой формулой, определением ретикулоцитов . Самый первый и главный показатель крови, что дает понять о наличии анемии и ее вида.
- Биохимия. Оценивается уровень лактатдегидрогеназ ы , билирубин и гаптоглобин в крови;
- Анализ мочи, на наличие уробилиногена, гемоглобинурия;
- Периферический мазок крови. Капля крови детально рассматривается под микроскопом и оценивают качество клеток;
- Тесты Кумбса на антитела к эритроцитам, которые атакуют свои клетки.
С целью проверки эритропоэза проводится аспирация костного мозга, и детально рассматриваются процесс образования эритроцитов. Также проводят УЗИ и КТ диагностику печени и селезенки.
Лечение
Протокол лечения гемолитической анемии зависит от многих факторов: причина развития заболевания, возраст больного, общее состояние организма, острое или хроническое состояние.
Если присутствует иммунный компонент показано принимать глюкокортикостероиды. Назначаются средние или высокие дозы метилпреднизолона с последующим снижением до поддерживающих доз. В тяжелых случаях применяют другую иммуносупрессивную терапию.
Онкологическое заболевание требует полноценной химии или лучевой терапии для переведения опухоли в стадию ремиссии.
К общей терапии гемолитической анемии всегда добавляется фолиевая кислота, которая способствует образованию новых клеток крови. Ритуксимаб, как препарат, что влияет на иммунную систему , применяется во второй и последующих линиях терапии
В случае острой анемии, что приводит к нарушению важных жизненных функций, по абсолютным показаниям врачи проводят гемотрансфузионную терапию. Она заключается в прямом восстановлении количества эритроцитов путем переливания крови.
Также при увеличении размеров и активности селезенки, проводят хирургическое удаления.
Стоит учитывать, что важно не только полноценное лечение, но и определенный способ жизни. Максимально оберегать себя от травм, воздействия низких температур. Проводить профилактику инфекционных заболеваний, беречь себя от контактов с больными и вовремя вакцинироваться.
Гемолитическая анемия
![Фото]()
Под гемолитической анемией понимают специфические болезни крови. Им свойственно сокращение цикла жизни красных кровяных телец. Наблюдается активное разрушение эритроцитов, тогда как новые не успевают образовываться в необходимом объеме. Уровень гемоглобина при этом остается нормальным. Гемолитические анемии бывают врожденными и приобретенными. В первом случае причиной отклонения являются генетически детерминированные изменения. Самыми распространенными их формами называют серповидную анемию и талассемию. Заболевания же приобретенные обусловлены выработкой антител к эритроцитам или же влиянием негативных факторов.
Информацию из данного раздела нельзя использовать для самодиагностики и самолечения. В случае боли или иного обострения заболевания диагностические исследования должен назначать только лечащий врач. Для постановки диагноза и правильного назначения лечения следует обратиться к профильному специалисту.
![Онлайн-консультация врача в Московской клинике]()
Симптомы
Главный признак подобных состояний — желтушный окрас кожи и слизистой. Это связано с выбросом большого количества билирубина при разрушении эритроцитов. Остальные общие признаки анемии:
- потемнение каловых масс и урины;
- озноб;
- рост в размерах селезенки и печени.
Если гемолитическая анемия спровоцирована отравлением организма химическими веществами, то в первое время присутствуют головная боль и разбитость. Затем пациент отмечает:
- тошноту;
- лихорадку;
- болезненные ощущения в правом подреберье;
- пурпурную мочу.
Если больному не оказывается корректная медицинская помощь, то через несколько суток развиваются желтуха и почечная недостаточность.
Что касается тяжелой наследственной мишеневидноклеточной анемии (талассемии), то ее признаки следующие:
- узкие глазные щели;
- недоразвитость в умственном или физическом плане;
- патологически измененные кости черепа, скелета;
- зеленоватый окрас кожи.
Гемолитическая анемия новорожденного характеризуется асцитом, отечностью. Параллельно с этим отмечается резкий и тонкий крик ребенка. Клинически определяется высокое содержание незрелых эритроцитов.
Заболеванию, диагностируемому у старших пациентов, свойственна закупорка мелких сосудов склеивающимися эритроцитами. Нередко наблюдаются длительно незаживающие трофические язвы.
Характер симптомов, тяжесть проявлений гемолитической анемии во многом зависят от формы. Приобретенное острое состояние вызывает внезапные приступы слабости, одышку после умеренных физических нагрузок, аритмию. Довольно быстро увеличиваются селезенка и печень. Хроническая форма протекает не так выраженно, все симптомы появляются по нарастающей на протяжении длительного периода.
![Фото Гемолитическая анемия]()
Причины болезни
Врожденная гемолитическая анемия обусловливается передачей аномального гена по наследству от одного или каждого из родителей. Вторая причина проблемы —внезапная мутация генов в процессе внутриутробного развития. Пациенты с гомозиготной анемией (аномалия в каждой хромосоме одной пары) редко живут долго, умирая в детском или подростковом возрасте.
Гемолитические приобретенные болезни провоцируются множеством причин. Среди них:
- повышенная чувствительность к медикаментам;
- продолжительное воздействие химических веществ;
- отравление ядами;
- ожоговая интоксикация;
- ряд паразитарных инвазий;
- бактериальные инфекции.
Существуют и иммунные причины, приводящие к гемолитической анемии. Это:
- дефицит витамина E;
- продуцирование антител к эритроцитам на фоне рака крови, лимфатической ткани, при других сбоях функционирования иммунитета;
- механическое повреждение красных кровяных телец, в том числе искусственными клапанами;
- несовместимость групп при переливании крови.
Какой врач лечит гемолитическую анемию?
Абсолютно каждый вид из группы данных заболеваний должен контролироваться врачом. Пациенту при первых же признаках анемии или подозрении на нее следует обратиться к такому врачу как:
Может понадобиться консультация терапевта, эндокринолога, иммунолога. На приеме специалист:
- анализирует жалобы пациента и анамнез заболевания;
- проводит визуальный осмотр;
- измеряет АД, прослушивает работу сердечной мышцы;
- направляет на клинический анализ крови;
- назначает УЗИ внутренних органов.
Важно при гемолитической анемии вовремя распознать симптомы и назначить лечение конкретной формы заболевания. Для уточнения диагноза прибегают к дополнительным мерам:
- определению уровня билирубина в урине;
- исследованию геометрии красных кровяных телец;
- пробе Кумбса;
- забору костного мозга на биопсию.
Эффективные методы лечения
Все способы купирования проявлений и избавления от гемолитической анемии определяются видом заболевания. Исходя из этого применяют:
- противомалярийные препараты;
- дезинтоксикационную терапию;
- кортикостероиды;
- хирургические методы (удаление селезенки).
Многократные и острые приступы гемолитической анемии требуют переливаний крови. Крайне важна тщательный контроль биоматериала.
Избавиться от проявлений наследственных заболеваний крови позволяет преимущественно спленэктомия. Консервативные методы на время облегчают состояние пациента, не обеспечивают защиту от рецидивов. Операцию проводят в период «затишья». Осложнения после вмешательства наблюдаются нечасто. Впоследствии нужно будет более тщательно следить за иммунитетом.
Талассемия, серповидноклеточная анемия поддаются лечению благодаря переливанию эритроцитарной массы, искусственных заменителей крови. Пациенту необходимо избегать нахождения в способствующих гипоксии условиях: недостаточное содержание кислорода, разреженный воздух.
Что если не лечить?
Даже 1 степень анемии у беременных без корректировки может привести к негативным последствиям для матери и ребенка. Есть риск:
- инфекции мочевых путей;
- гипостенурии;
- гематурии;
- раннего родоразрешения.
Тяжелая анемия существенно повышает возможность самопроизвольного аборта. Беременные с заболеваниями крови должны динамически наблюдаться у гинеколога и гематолога. Если проблема выявлена у ребенка, то без грамотного лечения наблюдается отставание в физическом развитии. Отсутствие аппетита, недостаток полезных веществ в организме приводят к низкому иммунитету и частым болезням.
Если анемия продолжает прогрессировать, грамотное лечение отсутствует, то возможно развитие:
- ишемии паренхимы, некроза тканей селезенки;
- сердечно-сосудистой недостаточности;
- острой почечной недостаточности;
- ДВС-синдрома;
- гемолитической комы.
Крайне опасен ДВС-синдром, способный развиться у разновозрастных пациентов. Кровь внутри сосудов свертывается, процесс сопровождается кровотечениями. Страдают органы, полости, слизистые оболочки и кожа. Предупредить необратимые и фатальные изменения позволяет только экстренная интенсивная терапия. Не менее опасны острые недостаточности, грозящие смертельным исходом.
Профилактика
Предупредить анемию получается далеко не всегда, но для ряда разновидностей существуют профилактические меры. Необходимо:
- определить резус-фактор на этапе планирования семьи;
- семьям с наследственными гемолитическими анемиями консультироваться у генетика;
- укреплять иммунитет;
- вести здоровый образ жизни.
Люди с предрасположенностью к анемии должны ежедневно следить за своим питанием. В основу рациона рекомендуется заложить продукты со сложными углеводами, аминокислотами, а также белки. В профилактических и лечебных целях составляют меню с акцентом на:
- говядину, индюшатину;
- бобовые;
- овощи;
- гречневую и овсяную крупу;
- сливочное, оливковое масло.
Салаты из овощей с зеленью, зерновые завтраки обеспечивают достаточное количество фолиевой кислоты. Регулярное употребление натурального меда способствует усвоению железа. Достаточно 1-2 ст. л. в сутки.
И профилактика, и лечение разнообразных симптомов гемолитической анемии требуют тщательного соблюдения особого режима питания. Важно отказаться от частого употребления острой, чрезмерно жирной и соленой пищи. Необходимо максимально сокращать содержание консервантов, усилителей вкуса.
Помимо контролируемого питания, в профилактических целях рекомендуют ежедневно прибегать к умеренным физическим нагрузкам. Это может быть плавание, йога, ЛФК, другие виды спорта. Их выбор определяется выносливостью и общим состоянием организма пациента. В качестве предупреждения анемии по назначению врача принимают препараты железа. Делать это нужно только после консультации с доктором, самолечение недопустимо.
Гемолитические анемии
![Гемолитические анемии]()
Гемолитические анемии – группа редких патологических состояний, которая характеризуется нарушением жизненного цикла эритроцитов, а точнее – преобладанием процессов их распада над формированием и развитием. В результате наблюдается большое количество продуктов их распада на фоне ускоренного эритропоэза – образования. В норме продолжительность жизни эритроцитов составляет от ста до ста двадцати суток, при анемии он сокращается до пятнадцати-двадцати дней. Деструктивные процессы происходят не только в сосудах, но и селезёнке, костном мозге и печени.
Гемолитическая анемия: причины
Согласно этиологическим факторам, выделяют две подгруппы гемолитической анемии.
- Генетические дефекты мембран красных кровяных телец;
- Аномалии их ферментных систем;
- Нарушения структуры гемоглобина.
- Аутоиммунные заболевания, для которых характерно производство антител против собственных тканей организма (новообразования злокачественной природы лимфатической и кроветворной тканей, системная красная волчанка, вирусное воспаление лёгких, инфекционный мононуклеоз);
- Повреждения эритроцитов вследствие механических воздействий при тяжёлых физических нагрузках – продолжительный бег или ходьба, болотная лихорадка, повышенное АД, установка протезов клапанов сердца или кровеносных сосудов, ожоги больших площадей тела. Вышеперечисленное может спровоцировать травмы и разрыв мембран изначально здоровых эритроцитов;
- Воздействие токсинов – мышьяка, тяжёлых металлов, алкоголя, уксусной кислоты или фармакологических препаратов в виде анальгетиков, сульфаниламидов.
Гемолитическая анемия: классификация
Группа гемолитических синдромов достаточно обширна и включает в себя разные формы, ознакомиться с которыми можно в нашей таблице:
- Мембранопатии – анемии, вызванные аномалиями их мембран (микросфероцитоз, акантоцитоз, овалоцитоз);
- Ферментопении – развиваются вследствие недостатка ферментов гликолиза, участвующих в образовании аденозинтрифосфата, прочие;
- Гемоглобинопатии – связанные с аномалиями структуры гемоглобина или неправильного соотношения его нормальных форм.
- Иммуногемолитические – развиваются из-за воздействия антител;
- Мембранопатии – спровоцированы аномалиями структуры мембран из-за различных воздействий;
- Механические – разрывы мембран здоровых эритроцитов из-за тяжёлых физических нагрузок, хирургических вмешательств, ожогов;
- Токсические – воздействие токсинами, биологическими ядами, приём лекарств.
Гемолитическая анемия: симптомы
Клинические проявления гемолитической анемии зависят от того, к какой группе и форме она относится.
- Повышение общей температуры тела;
- Ощущение слабости и головокружение;
- Болевая симптоматика в области живота, рвота;
- Желтуха кожных покровов;
- Тёмно-коричневый цвет кала;
- Увеличение селезёнки и печени.
- Бледной желтизной кожных покровов;
- Гепатолиенальным синдромом (ощущение тяжести в правом и левом подреберье).
- В тяжёлых случаях развивается ощущение слабости, появляется одышка и сильное сердцебиение, урина окрашивается в тёмный, нередко чёрный цвет.
- бледность кожи;
- патологические переломы костей;
- синовиальное поражение суставов;
- язвы ног;
- восприимчивость к инфекциям.
- лихорадка;
- ощущение сильной слабости;
- одышка при несущественных нагрузках;
- болевые ощущения в пояснице;
- желтушность кожных покровов;
- увеличение печени и селезёнки.
- Осложнения – гангренозные поражения пальцев верхних и нижних конечностей.
- Развитие лихорадки;
- Сонливость;
- Болевые ощущения в области живота и поясницы;
- Увеличение печени и селезёнки;
- Аномально тёмный цвет урины.
- Ощущение слабости;
- Тёмный цвет урины;
- Искривление позвоночника в области поясницы.
- Ощущение слабости, которое усиливается;
- Болевая симптоматика в области правого подреберья и поясницы;
- Повышение температуры тела;
- Желтуха;
- Печёночная и почечная недостаточность.
Гемолитическая анемия: диагностика
Перед тем, как назначать лечение, гематологи ЦЭЛТ проводят всестороннее обследование для того, чтобы определить форму анемии и установить причины её развития. Для этого пациенту назначают:
- Лабораторные анализы крови, урины и кала;
- Цитологическое исследование пунктата костного мозга;
- УЗ-сканирование селезёнки и печени.
Гемолитическая анемия: лечение
- Комплекс мер, направленных на снижение активности и концентрации токсинов в организме;
- Форсированный диурез для естественной детоксикации;
- Инъекции антидотов;
- Очищение крови аппаратом «искусственная почка».
В периоды гемолитических кризов пациентам вводят в кровоток индивидуально подобранные лекарственные растворы и плазму крови, назначают приём витаминных комплексов, а также гормонов и антибиотиков (при необходимости).
В отличие от врождённых, многие из приобретённых форм полностью излечиваются. В случае с первыми, при правильном подходе, можно добиться продолжительной ремиссии. Если у пациента развились серьёзные осложнения – прогноз неблагоприятный. В отделении гематологии ЦЭЛТ ведут приём кандидаты, доктора и профессоры медицинских наук с опытом практической и научной работы от двадцати пяти лет. Вы можете записаться к ним на приём онлайн, через наш сайт или обратившись к нашим операторам. Больные, страдающие от камней в почках, могут пройти в нашей клинике процедуру лазерной литотрипсии.
Читайте также: